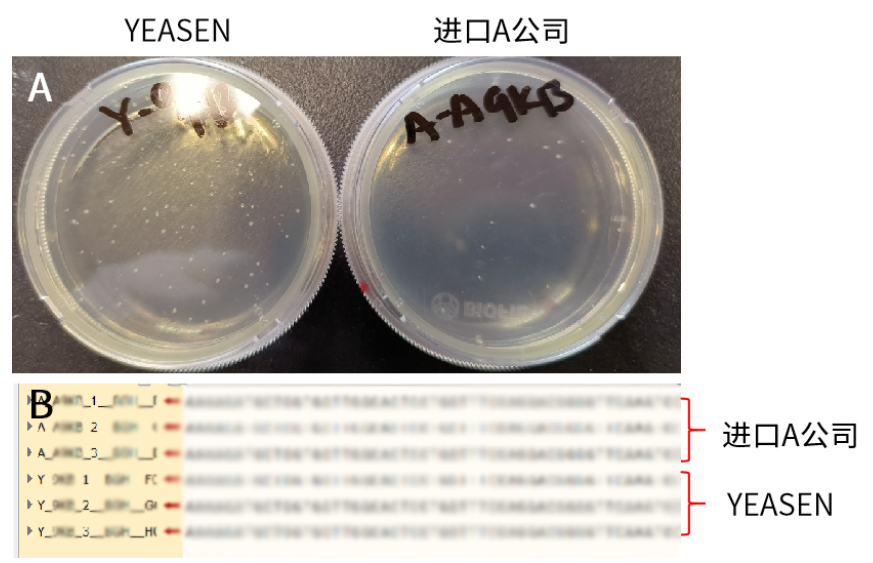
新闻图片2
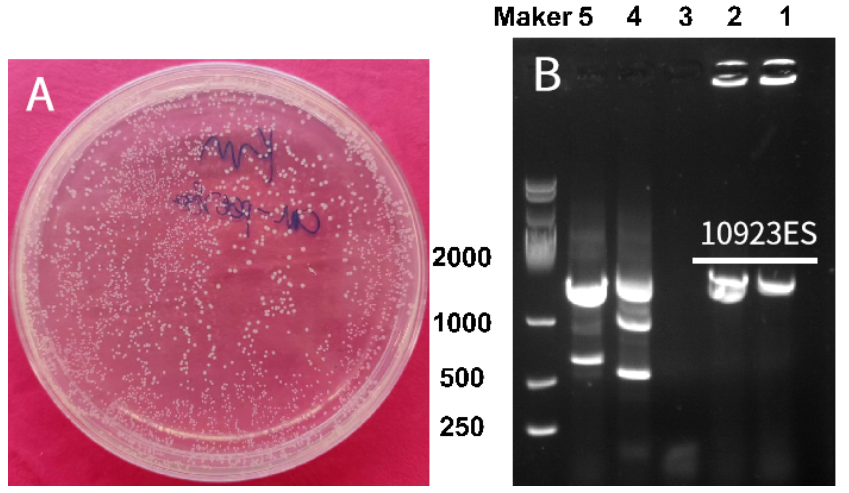
新闻图片3
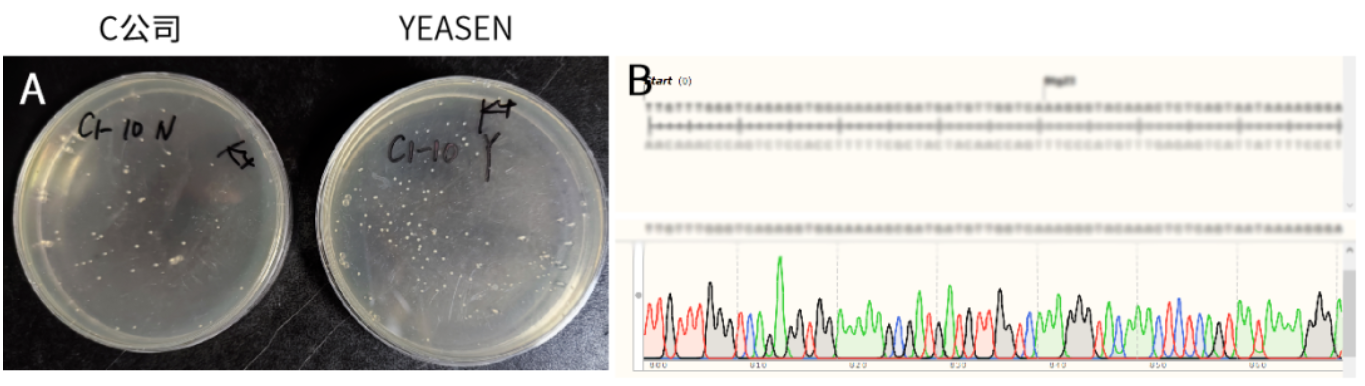
新闻图片5
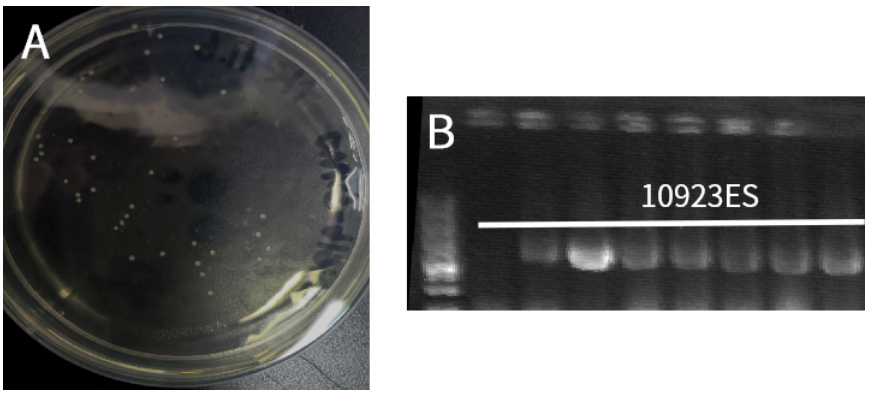
新闻图片6
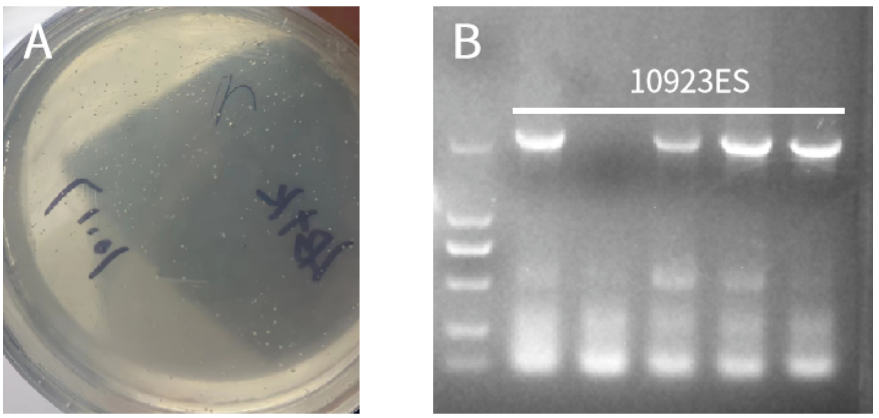
新闻图片7
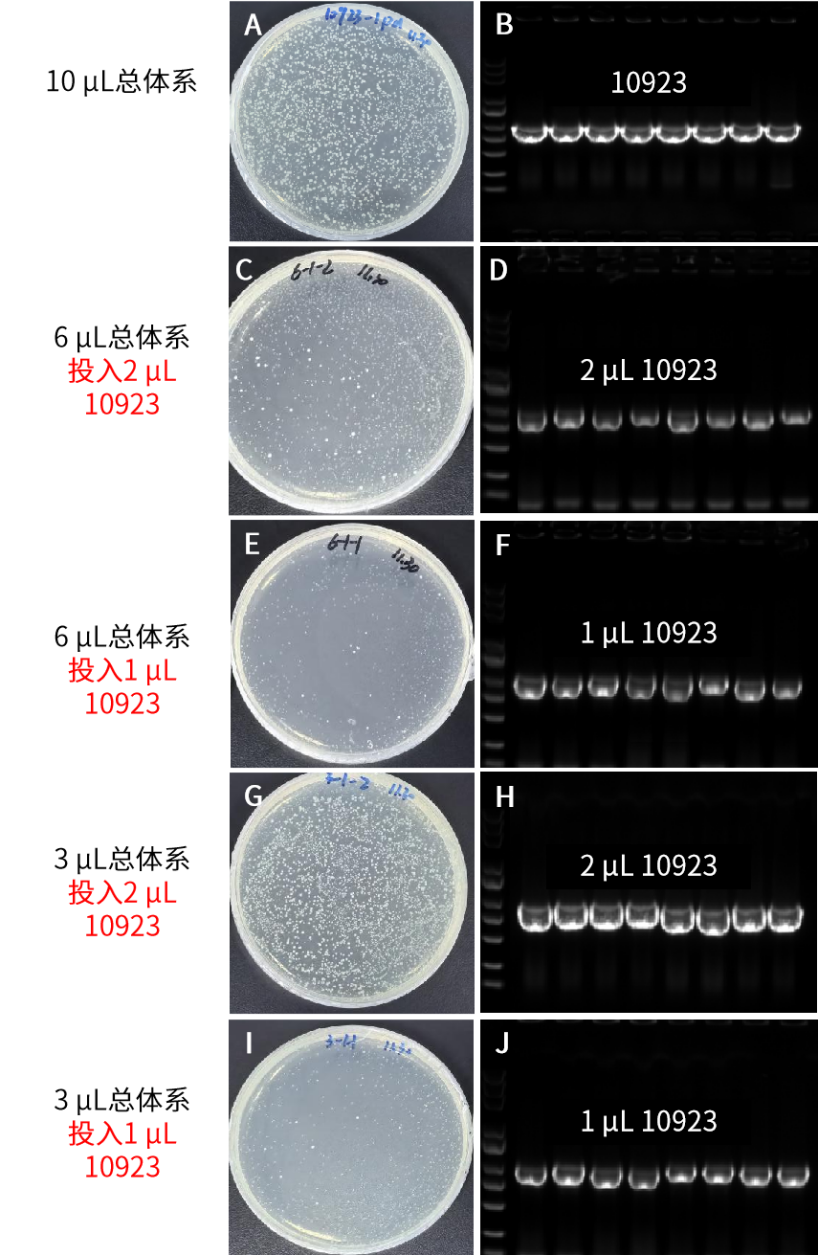
新闻图片11

翌圣生物科技(上海)股份有限公司品牌商
19 年
手机商铺
- NaN
- 0.6000000000000001
- 1.6
- 0.6000000000000001
- 3.6
翌圣生物科技(上海)股份有限公司
入驻年限:19 年
- 联系人:
翌圣生物
- 所在地区:
上海
- 业务范围:
体外诊断、耗材、技术服务、抗体、ELISA 试剂盒、细胞库 / 细胞培养、试剂
- 经营模式:
生产厂商
推荐产品
公司新闻/正文
市场好评 | 6 μL超小体系连接,一步法快速克隆连接效率超乎你的想象!
556 人阅读发布时间:2023-12-26 17:38
翌圣新品通用型多片段一步法快速克隆试剂盒(Hieff Clone® Universal II One Step Cloning Kit,Cat#10923ES)上市至今,经过大量的内部测试和市场验证,产品性能优,客户反馈效果好,面对如此优秀的作品,小翌已经迫不及待地想和大家一同分享近期收到的反馈啦~
客户试用反馈
6 μL小体系长载体高效率重组
中国科学院基础医学与肿瘤研究所:单片段连接
实验信息:载体11786 bp,目的片段700 bp

图1. 10923ES在6 μL小反应体系下,低浓度长载体(32 ng)连接单片段,连接效率高于竞品,阳性率100%。A:重组转化平板。B:插入片段测序鉴定图。
客户评价:效果很好!
低浓度载体高效率重组
上海科技大学:单片段连接
实验信息:载体9000 bp,目的片段1000 bp
图2. 10923ES在低浓度载体(50 ng)条件下,连接单片段,连接效率高,菌落数多于竞品,阳性率100%。A:重组转化平板。B:插入片段测序鉴定图。
小体系低浓度载体高效率重组
上海交通大学:单片段连接
实验信息:载体5369 bp,目的片段1589 bp
图3. 10923ES在10 μL小反应体系下,低浓度载体(30 ng)连接单片段,阳性率100%。A:重组转化平板。B:插入片段PCR鉴定电泳图,泳道1-5分别为菌落1,菌落2,阴性对照,阳性对照(基因组作为模版),阳性对照(PCR纯化片段作为模版)。
客户评价:实验效果较好,挑选两个克隆点都连接成功!
小体系5分钟快速高效率重组
四川农业大学:单片段连接
实验信息:载体7200 bp,目的片段1800 bp

图4. 10923ES在10 μL小反应体系下,快速5 min连接单片段,连接效率高,阳性率高(11/12)。A:重组转化平板。B:插入片段PCR鉴定电泳图。
超短片段高效率重组
浙江大学:单片段连接
实验信息:载体5000 bp,目的片段72 bp
图5. 10923ES连接72 bp超短片段(20 ng),菌落数多于竞品,阳性率高。A:重组转化平板。B:插入片段测序鉴定图。
客户评价:效果较好!
小体系5分钟快速高效率重组
武汉大学:单片段连接
实验信息:载体1600 bp,目的片段1000 bp
图6. 10923ES在10 μL小反应体系下,阳性率高。A:重组转化平板。B:插入片段PCR鉴定电泳图。
客户评价:试剂效果不错,克隆效率高!
小体系长载体高效率重组
河南农业大学:单片段连接
实验信息:载体10000 bp,目的片段1011 bp
图7. 10923ES在10 μL小反应体系下,低浓度长载体(50 ng)连接单片段,阳性率高。A:重组转化平板。B:插入片段PCR鉴定电泳图。
客户评价:好用!
多片段低浓度载体高效率重组
中国科学技术大学:二片段连接
实验信息:载体5400 bp,目的片段1500 bp,66 bp

图8. 10923ES在低浓度载体(45 ng)下连接二片段,菌落数多,阳性率高。A:重组转化平板。B:插入片段测序鉴定图。
客户评价:使用较为方便!
多片段高效率重组
上海科技大学:三片段连接
实验信息:载体8253 bp,目的片段1246 bp,970 bp,330 bp

图9. 10923ES连接三片段,连接效率高,阳性率100%。A:重组转化平板。B:插入片段PCR鉴定电泳图。
明星新品推荐
翌圣新品通用型多片段一步法快速克隆试剂盒(Cat#10923ES),该产品连接效率高,菌落数多,小体系连接不仅省酶,也省载体/片段!性能测试超小体系连接可至3 μL,单片段连接酶使用量低至1 μL!
产品特点

产品性能
超小体系单片段连接
图10:10923ES超小体系连接1 kb单片段,连接效率高,菌落数多,阳性率达100%。3 μL总体系连接,10923ES的投入量可低至1 μL。A&C&E&I:50 ng载体(11.6 kb)+10 ng片段(1 kb);G:25 ng载体+5 ng片段。B&D&F&H&J:插入片段PCR鉴定电泳图。
超小体系三片段连接

图11:10923ES超小体系连接三片段,连接效率,阳性率达100%。3 μL总体系连接,10923ES的投入量可低至2 μL。A&C&E:25 ng载体(11.6 kb)+各10 ng片段(1 kb+1.6 kb+1.8 kb)。B&D&F:插入片段PCR鉴定电泳图。
10923ES商品订购通道
| 产品定位 |
名称 |
货号 |
规格 |
| 1-7片段一步法定向连接,最快5分钟完成重组反应 |
Hieff Clone® Universal II One Step Cloning Kit |
10923ES20/50 |
20 T/50 T |
相关产品
| 产品定位 |
名称 |
货号 |
规格 |
| 单片段一步克隆,已发文章累计IF达到1000+ |
Hieff Clone® Plus One Step Cloning Kit一步法快速克隆试剂盒 |
10911ES20/50 |
20 T/50 T |
| 1-6片段一步克隆,最快5分钟完成重组反应 |
Hieff Clone® Universal One Step Cloning Kit通用型一步法快速克隆试剂盒 |
10922ES20/50 |
20 T/50 T |
| TOPO克隆-兼容TA/平末端 |
Hieff Clone® Universal Zero TOPO TA/Blunt Cloning Kit |
10906ES20 |
20 T |
| 5s/kb,保真保快 |
2× Hieff Canace® AdvanceFast PCR Master Mix (With Dye) |
10164ES03/08 |
1 mL/5×1 mL |
| 快速PCR,快至1s/kb |
2×Hieff® Ultra-Rapid HotStart PCR Master Mix(with Dye) |
10157ES03/08 |
1 mL/5×1 mL |








